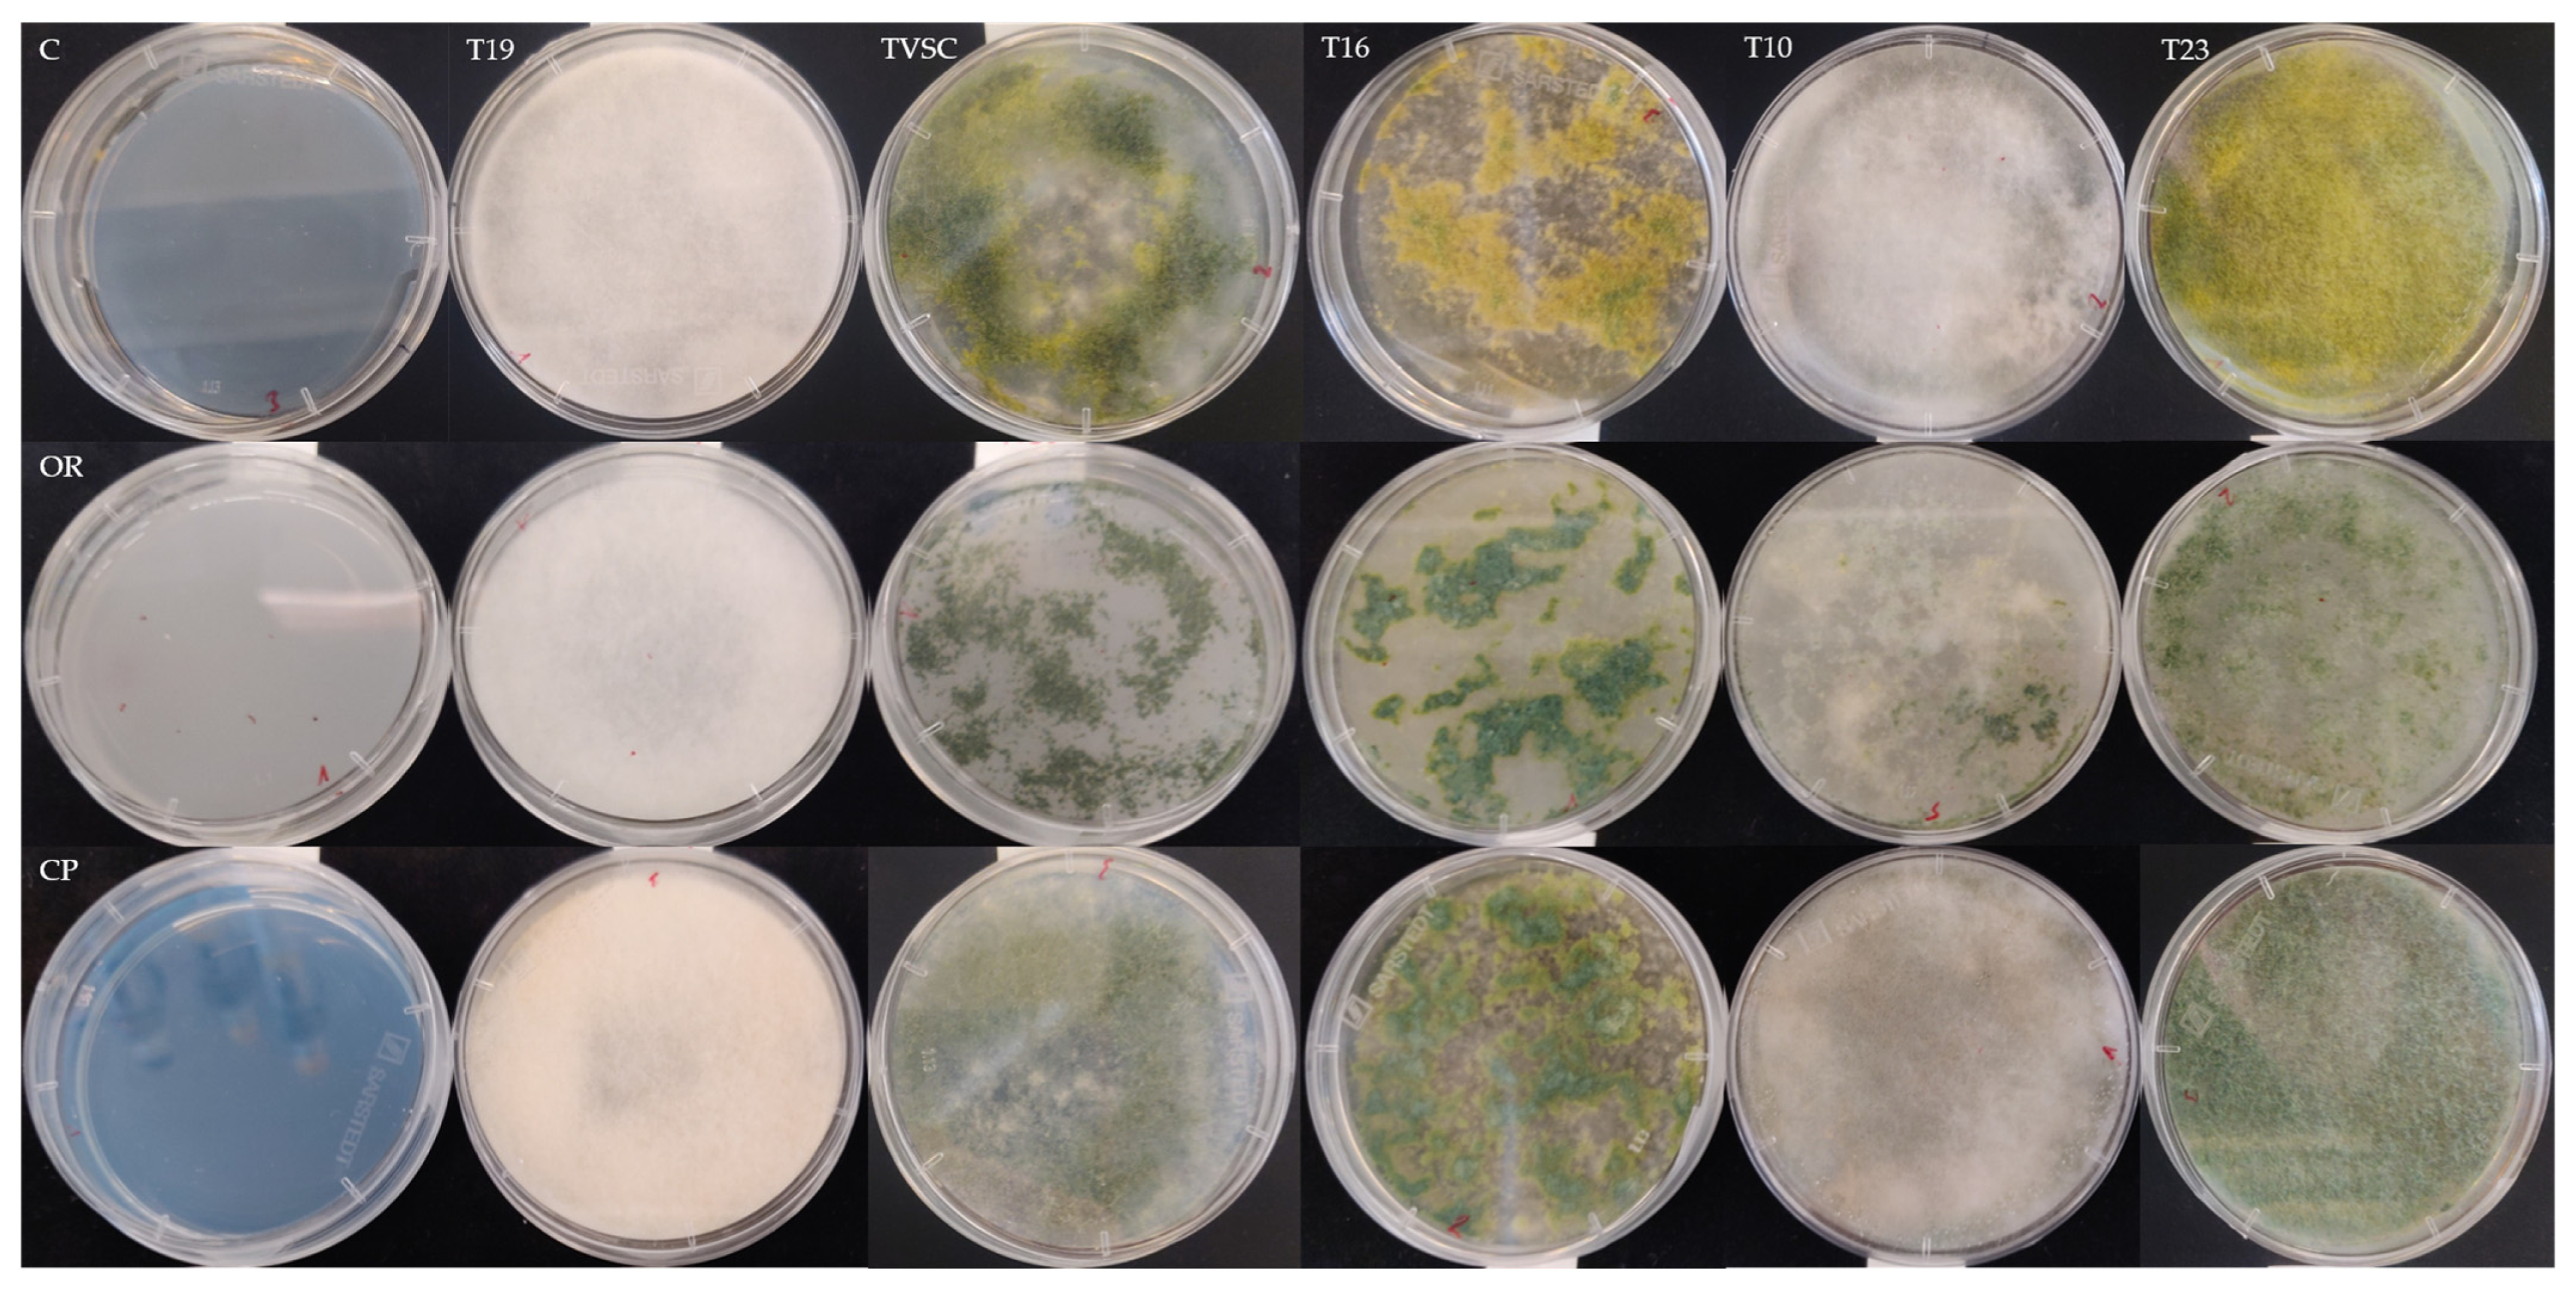
Antibiotics 13 00912 g0a1

Efficacy of Trichoderma spp. and Kosakonia sp. Both Independently and Combined with Fungicides against Botrytis cinerea on Strawberries
Abstract
:1. Introduction
2. Results
2.1. Tolerance of Trichoderma spp. to Various Fungicides in Terms of Growth and Sporulation
2.2. Growth of Kosakonia sp. on Fungicide-Amended Medium
2.3. In Planta Assessment of the Potential of BCAs and Fungicide Combinations against Botrytis cinerea
3. Discussion
4. Materials and Methods
4.1. Micoorganisms and Media
4.2. Preparation of Conidial Suspensions of Trichoderma spp.
4.3. Evaluation of Growth and Sporulation of Trichoderma on Fungicide-Amended Media
4.4. Assessing the Effect of Fungicides, Including Cuprozin Progress, on the Growth of Kosakonia
4.5. Effects of BCAs Alone or in Combination with Fungicides on B. cinerea under Greenhouse Conditions
4.6. Statistical Analysis
5. Conclusions
Author Contributions
Funding
Institutional Review Board Statement
Informed Consent Statement
Data Availability Statement
Conflicts of Interest
Appendix A
References
- Hernández-Martínez, N.R.; Blanchard, C.; Wells, D.; Salazar-Gutiérrez, M.R. Current State and Future Perspectives of Commercial Strawberry Production: A Review. Sci. Hortic. 2023, 312, 111893. [Google Scholar] [CrossRef]
- Bhat, R.; Geppert, J.; Funken, E.; Stamminger, R. Consumers Perceptions and Preference for Strawberries—A Case Study from Germany. Int. J. Fruit Sci. 2015, 15, 405–424. [Google Scholar] [CrossRef]
- Bhat, R.; Stamminger, R. Preserving Strawberry Quality by Employing Novel Food Preservation and Processing Techniques—Recent Updates and Future Scope—An Overview. J. Food Process Eng. 2015, 38, 536–554. [Google Scholar] [CrossRef]
- Giampieri, F.; Tulipani, S.; Alvarez-Suarez, J.M.; Quiles, J.L.; Mezzetti, B.; Battino, M. The Strawberry: Composition, Nutritional Quality, and Impact on Human Health. Nutrition 2012, 28, 9–19. [Google Scholar] [CrossRef]
- Colquhoun, T.A.; Levin, L.A.; Moskowitz, H.R.; Whitaker, V.M.; Clark, D.G.; Folta, K.M. Framing the Perfect Strawberry: An Exercise in Consumer-Assisted Selection of Fruit Crops. J. Berry Res. 2012, 2, 45–61. [Google Scholar] [CrossRef]
- Wimberley, R.C.; Harris, C.K.; Molnar, J.J.; Tomazic, T.J. The Social Risks of Agriculture: Americans Speak Out on Food, Farming, and the Environment; Praeger Publishers: Westport, CT, USA, 2002; ISBN 978-0-275977658. [Google Scholar]
- Petrasch, S.; Knapp, S.J.; van Kan, J.A.L.; Blanco-Ulate, B. Grey Mould of Strawberry, a Devastating Disease Caused by the Ubiquitous Necrotrophic Fungal Pathogen Botrytis cinerea. Mol. Plant Pathol. 2019, 20, 877–892. [Google Scholar] [CrossRef]
- Garrido, C.; Carbú, M.; Fernández-Acero, F.J.; González-Rodríguez, V.E.; Cantoral, J.M. New Insights in the Study of Strawberry Fungal Pathogens. Genes Genomes Genom. 2011, 5, 24–39. [Google Scholar]
- Daugaard, H. Cultural Methods for Controlling Botrytis cinerea Pers. in Strawberry. Biol. Agric. Hortic. 1999, 16, 351–361. [Google Scholar] [CrossRef]
- Rosslenbroich, H.-J.; Stuebler, D. Botrytis cinerea—History of Chemical Control and Novel Fungicides for Its Management. Crop Prot. 2000, 19, 557–561. [Google Scholar] [CrossRef]
- Pande, S.; Sharma, M.; Kishore, G.K.; Shivram, L.; Mangala, U.N. Characterization of Botrytis cinerea Isolates from Chickpea: DNA Polymorphisms, Cultural, Morphological and Virulence Characteristics. Afr. J. Biotechnol. 2010, 9, 7961–7967. [Google Scholar] [CrossRef]
- Strømeng, G.M.; Hjeljord, L.G.; Stensvand, A. Relative Contribution of Various Sources of Botrytis cinerea Inoculum in Strawberry Fields in Norway. Plant Dis. 2009, 93, 1305–1310. [Google Scholar] [CrossRef] [PubMed]
- Strømeng, G.M.; Stensvand, A. Overwintering of Botrytis cinerea in Strawberry Fields in Norway. Integr. Plant Prot. Orchard.—Soft Fruits 2003, 26, 181–186. [Google Scholar]
- Carisse, O. Epidemiology and Aerobiology of Botrytis spp. In Botrytis—The Fungus, the Pathogen and its Management in Agricultural Systems; Fillinger, S., Elad, Y., Eds.; Springer International Publishing: Cham, Switzerland, 2016; pp. 127–148. ISBN 978-3-319-23371-0. [Google Scholar]
- Cole, L.; Dewey, F.M.; Hawes, C.R. Infection Mechanisms of Botrytis Species: Pre-Penetration and Pre-Infection Processes of Dry and Wet Conidia. Mycol. Res. 1996, 100, 277–286. [Google Scholar] [CrossRef]
- Edlich, W.; Lorenz, G.; Lyr, H.; Nega, E.; Pommer, E.-H. New Aspects on the Infection Mechanism of Botrytis cinerea Pers. Neth. J. Plant Pathol. 1989, 95, 53–62. [Google Scholar] [CrossRef]
- Jarvis, W.R. The Infection of Strawberry and Raspberry Fruits by Botrytis cinerea Fr. Ann. Appl. Biol. 1962, 50, 569–575. [Google Scholar] [CrossRef]
- Holz, G.; Coertze, S.; Williamson, B. The Ecology of Botrytis on Plant Surfaces. In Botrytis: Biology, Pathology and Control; Elad, Y., Williamson, B., Tudzynski, P., Delen, N., Eds.; Springer Netherlands: Dordrecht, The Netherlands, 2007; pp. 9–27. ISBN 978-1-4020-2626-3. [Google Scholar]
- Maas, J.L. (Ed.) Compendium of Strawberry Diseases; American Phytopathological Society: St. Paul, MN, USA, 1984; ISBN 0-89054-054-3. [Google Scholar]
- Williamson, B.; Tudzynski, B.; Tudzynski, P.; Van Kan, J.A.L. Botrytis cinerea: The Cause of Grey Mould Disease. Mol. Plant Pathol. 2007, 8, 561–580. [Google Scholar] [CrossRef]
- Leroux, P.; Fritz, R.; Debieu, D.; Albertini, C.; Lanen, C.; Bach, J.; Gredt, M.; Chapeland, F. Mechanisms of Resistance to Fungicides in Field Strains of Botrytis cinerea. Pest Manag. Sci. 2002, 58, 876–888. [Google Scholar] [CrossRef]
- Elmer, P.A.G.; Reglinski, T. Biosuppression of Botrytis cinerea in Grapes. Plant Pathol. 2006, 55, 155–177. [Google Scholar] [CrossRef]
- Brandhorst, T.T.; Klein, B.S. Uncertainty Surrounding the Mechanism and Safety of the Post-Harvest Fungicide Fludioxonil. Food Chem. Toxicol. 2019, 123, 561–565. [Google Scholar] [CrossRef]
- Waechter, F.; Weber, E.; Hertner, T.; May-Hertl, U. Chapter 89—Cyprodinil: A Fungicide of the Anilinopyrimidine Class. In Hayes’ Handbook of Pesticide Toxicology, 3rd ed.; Krieger, R., Ed.; Academic Press: New York, NY, USA, 2010; pp. 1903–1913. ISBN 978-0-12-374367-1. [Google Scholar]
- Yang, L.-N.; He, M.-H.; Ouyang, H.-B.; Zhu, W.; Pan, Z.-C.; Sui, Q.-J.; Shang, L.-P.; Zhan, J. Cross-Resistance of the Pathogenic Fungus Alternaria alternata to Fungicides with Different Modes of Action. BMC Microbiol. 2019, 19, 205. [Google Scholar] [CrossRef]
- Tamm, L.; Thuerig, B.; Apostolov, S.; Blogg, H.; Borgo, E.; Corneo, P.E.; Fittje, S.; de Palma, M.; Donko, A.; Experton, C.; et al. Use of Copper-Based Fungicides in Organic Agriculture in Twelve European Countries. Agronomy 2022, 12, 673. [Google Scholar] [CrossRef]
- Lamichhane, J.R.; Osdaghi, E.; Behlau, F.; Köhl, J.; Jones, J.B.; Aubertot, J.-N. Thirteen Decades of Antimicrobial Copper Compounds Applied in Agriculture. A Review. Agrononomy Sustain. Dev. 2018, 38, 28. [Google Scholar] [CrossRef]
- Richardson, H.W. Copper Fungicides/Bactericides. In Handbook of Copper Compounds and Applications; CRC Press: Boca Raton, FL, USA, 1997; pp. 93–122. ISBN 978-0-8247-8998-5. [Google Scholar]
- Montag, J.; Schreiber, L.; Schönherr, J. An In Vitro Study of the Nature of Protective Activities of Copper Sulphate, Copper Hydroxide and Copper Oxide Against Conidia of Venturia inaequalis. J. Phytopathol. 2006, 154, 474–481. [Google Scholar] [CrossRef]
- Gupta, P.K. Chapter 45—Toxicity of Fungicides. In Veterinary Toxicology, 3rd ed.; Gupta, R.C., Ed.; Academic Press: Cambridge, MA, USA, 2018; pp. 569–580. ISBN 978-0-12-811410-0. [Google Scholar]
- Wang, Z.; Cang, T.; Qi, P.; Zhao, X.; Xu, H.; Wang, X.; Zhang, H.; Wang, X. Dissipation of Four Fungicides on Greenhouse Strawberries and an Assessment of Their Risks. Food Control 2015, 55, 215–220. [Google Scholar] [CrossRef]
- Winter, C.K.; Katz, J.M. Dietary Exposure to Pesticide Residues from Commodities Alleged to Contain the Highest Contamination Levels. J. Toxicol. 2011, 2011, 589674. [Google Scholar] [CrossRef]
- EWG Shoppers Guide to Pesticides in Produce. Available online: https://www.ewg.org/foodnews/ (accessed on 30 December 2023).
- Card, S.D.; Walter, M.; Jaspers, M.V.; Sztejnberg, A.; Stewart, A. Targeted Selection of Antagonistic Microorganisms for Control of Botrytis cinerea of Strawberry in New Zealand. Australas. Plant Pathol. 2009, 38, 183–192. [Google Scholar] [CrossRef]
- Harman, G.E.; Howell, C.R.; Viterbo, A.; Chet, I.; Lorito, M. Trichoderma Species—Opportunistic, Avirulent Plant Symbionts. Nat. Rev. Microbiol. 2004, 2, 43–56. [Google Scholar] [CrossRef]
- Marín, A.; Atarés, L.; Chiralt, A. Improving Function of Biocontrol Agents Incorporated in Antifungal Fruit Coatings: A Review. Biocontrol Sci. Technol. 2017, 27, 1220–1241. [Google Scholar] [CrossRef]
- Illueca, F.; Vila-Donat, P.; Calpe, J.; Luz, C.; Meca, G.; Quiles, J.M. Antifungal Activity of Biocontrol Agents In Vitro and Potential Application to Reduce Mycotoxins (Aflatoxin B1 and Ochratoxin A). Toxins 2021, 13, 752. [Google Scholar] [CrossRef]
- Walker, R.; Powell, A.A.; Seddon, B. Bacillus Isolates from the Spermosphere of Peas and Dwarf French Beans with Antifungal Activity against Botrytis cinerea and Pythium Species. J. Appl. Microbiol. 1998, 84, 791–801. [Google Scholar] [CrossRef]
- Cook, D.W.M.; Long, P.G.; Ganesh, S.; Cheah, L.-H. Attachment Microbes Antagonistic against Botrytis cinerea—Biological Control and Scanning Electron Microscope Studies In Vivo. Ann. Appl. Biol. 1997, 131, 503–518. [Google Scholar] [CrossRef]
- Elad, Y. Trichoderma harzianum T39 Preparation for Biocontrol of Plant Diseases-Control of Botrytis cinerea, Sclerotinia sclerotiorum and Cladosporium fulvum. Biocontrol Sci. Technol. 2000, 10, 499–507. [Google Scholar] [CrossRef]
- Benítez, T.; Rincón, A.M.; Limón, M.C.; Codón, A.C. Biocontrol Mechanism of Trichoderma Strains. Int. Microbiol. 2004, 7, 249–260. [Google Scholar] [PubMed]
- Schuster, A.; Schmoll, M. Biology and Biotechnology of Trichoderma. Appl. Microbiol. Biotechnol. 2010, 87, 787–799. [Google Scholar] [CrossRef]
- Steyaert, J.M.; Ridgway, H.J.; Elad, Y.; Stewart, A. Genetic Basis of Mycoparasitism: A Mechanism of Biological Control by Species of Trichoderma. New Zealand J. Crop Hortic. Sci. 2003, 31, 281–291. [Google Scholar] [CrossRef]
- Mukherjee, P.K.; Mendoza-Mendoza, A.; Zeilinger, S.; Horwitz, B.A. Mycoparasitism as a Mechanism of Trichoderma-Mediated Suppression of Plant Diseases. Fungal Biol. Rev. 2022, 39, 15–33. [Google Scholar] [CrossRef]
- Nawrocka, J.; Małolepsza, U. Diversity in Plant Systemic Resistance Induced by Trichoderma. Biol. Control. 2013, 67, 149–156. [Google Scholar] [CrossRef]
- Bisen, K.; Keswani, C.; Patel, J.S.; Sarma, B.K.; Singh, H.B. Trichoderma spp.: Efficient Inducers of Systemic Resistance in Plants. In Microbial-mediated Induced Systemic Resistance in Plants; Choudhary, D.K., Varma, A., Eds.; Springer Nature: Singapore, 2016; pp. 185–195. ISBN 978-981-10-0388-2. [Google Scholar]
- El-Hasan, A.; Walker, F.; Schöne, J.; Buchenauer, H. Antagonistic Effect of 6-Pentyl-Alpha-Pyrone Produced by Trichoderma harzianum toward Fusarium moniliforme. J. Plant Dis. Prot. 2007, 114, 62–68. [Google Scholar] [CrossRef]
- Verma, M.; Brar, S.K.; Tyagi, R.D.; Surampalli, R.Y.; Valéro, J.R. Antagonistic Fungi, Trichoderma spp.: Panoply of Biological Control. Biochem. Eng. J. 2007, 37, 1–20. [Google Scholar] [CrossRef]
- Vinale, F.; Sivasithamparam, K.; Ghisalberti, E.L.; Marra, R.; Woo, S.L.; Lorito, M. Trichoderma–Plant–Pathogen Interactions. Soil Biol. Biochem. 2008, 40, 1–10. [Google Scholar] [CrossRef]
- Keswani, C.; Mishra, S.; Sarma, B.K.; Singh, S.P.; Singh, H.B. Unraveling the Efficient Applications of Secondary Metabolites of Various Trichoderma spp. Appl. Microbiol. Biotechnol. 2014, 98, 533–544. [Google Scholar] [CrossRef]
- Sivan, A.; Chet, I. Degradation of Fungal Cell Walls by Lytic Enzymes of Trichoderma harzianum. Microbiology 1989, 135, 675–682. [Google Scholar] [CrossRef]
- Metcalf, D.A.; Wilson, C.R. The Process of Antagonism of Sclerotium cepivorum in White Rot Affected Onion Roots by Trichoderma koningii. Plant Pathol. 2001, 50, 249–257. [Google Scholar] [CrossRef]
- Gruber, S.; Seidl-Seiboth, V. Self versus Non-Self: Fungal Cell Wall Degradation in Trichoderma. Microbiology 2012, 158, 26–34. [Google Scholar] [CrossRef]
- Santos, A.J.C.; Divina, C.C.; Pineda, F.G.; Lopez, L.L.M.A. In Vitro Evaluation of the Antagonistic Activity of Trichoderma sp. against Fusarium verticillioides. Int. J. Agric. Technol. 2017, 13, 2539–2548. [Google Scholar]
- El-Hasan, A.; Schöne, J.; Höglinger, B.; Walker, F.; Voegele, R.T. Assessment of the Antifungal Activity of Selected Biocontrol Agents and Their Secondary Metabolites against Fusarium graminearum. Eur. J. Plant Pathol. 2018, 150, 91–103. [Google Scholar] [CrossRef]
- El-Hasan, A.; Walker, F.; Klaiber, I.; Schöne, J.; Pfannstiel, J.; Voegele, R.T. New Approaches to Manage Asian Soybean Rust (Phakopsora pachyrhizi) Using Trichoderma spp. or Their Antifungal Secondary Metabolites. Metabolites 2022, 12, 507. [Google Scholar] [CrossRef]
- Ghisalberti, E.L.; Rowland, C.Y. Antifungal Metabolites from Trichoderma harzianum. J. Nat. Prod. 1993, 56, 1799–1804. [Google Scholar] [CrossRef]
- Khan, R.A.A.; Najeeb, S.; Hussain, S.; Xie, B.; Li, Y. Bioactive Secondary Metabolites from Trichoderma spp. against Phytopathogenic Fungi. Microorganisms 2020, 8, 817. [Google Scholar] [CrossRef]
- El-Hasan, A.; Walker, F.; Schöne, J.; Buchenauer, H. Detection of viridiofungin A and other antifungal metabolites excreted by Trichoderma harzianum active against different plant pathogens. Eur. J. Plant Pathol. 2009, 124, 457–470. [Google Scholar] [CrossRef]
- Jan-Roblero, J.; Cruz-Maya, J.A.; Barajas, C.G. Chapter 12—Kosakonia. In Beneficial Microbes in Agro-Ecology; Amaresan, N., Senthil Kumar, M., Annapurna, K., Kumar, K., Sankaranarayanan, A., Eds.; Academic Press: Cambridge, MA, USA, 2020; pp. 213–231. ISBN 978-0-12-823414-3. [Google Scholar]
- Lambrese, Y.; Guiñez, M.; Calvente, V.; Sansone, G.; Cerutti, S.; Raba, J.; Sanz, M.I. Production of Siderophores by the Bacterium Kosakonia radicincitans and Its Application to Control of Phytopathogenic Fungi. Bioresour. Technol. Rep. 2018, 3, 82–87. [Google Scholar] [CrossRef]
- Ons, L.; Bylemans, D.; Thevissen, K.; Cammue, B.P.A. Combining Biocontrol Agents with Chemical Fungicides for Integrated Plant Fungal Disease Control. Microorganisms 2020, 8, 1930. [Google Scholar] [CrossRef]
- Raymaekers, K.; Ponet, L.; Holtappels, D.; Berckmans, B.; Cammue, B.P.A. Screening for Novel Biocontrol Agents Applicable in Plant Disease Management—A Review. Biol. Control. 2020, 144, 104240. [Google Scholar] [CrossRef]
- Sylla, J.; Alsanius, B.W.; Krüger, E.; Wohanka, W. Control of Botrytis cinerea in Strawberries by Biological Control Agents Applied as Single or Combined Treatments. Eur. J. Plant Pathol. 2015, 143, 461–471. [Google Scholar] [CrossRef]
- Song, J.; Lei, T.; Hao, X.; Yuan, H.; Sun, W.; Chen, S. Synergistic Effects of Clonostachys rosea Isolates and Succinate Dehydrogenase Inhibitors Fungicides against Gray Mold on Tomato. Microorganisms 2023, 11, 20. [Google Scholar] [CrossRef]
- Widmer, T.L. Compatibility of Trichoderma asperellum Isolates to Selected Soil Fungicides. Crop Prot. 2019, 120, 91–96. [Google Scholar] [CrossRef]
- Maheshwary, N.P.; Gangadhara, N.B.; Amoghavarsha, C.; Naik, S.K.; Satish, K.M.; Nandish, M.S. Compatibility of Trichoderma asperellum with Fungicides. Pharma Innov. J. 2020, 9, 136–140. [Google Scholar]
- Saxena, D.; Tewari, A.; Rai, D. The In Vitro Effect of Some Commonly Used Fungicides, Insecticides and Herbicides for Their Compatibility with Trichoderma harzianum PBT23. World Appl. Sci. J. 2014, 31, 444–448. [Google Scholar] [CrossRef]
- Elad, Y.; Zimand, G.; Zuriel, S.; Chet, I. Use of Trichoderma harzianum in Combination or Alternation with Fungicides to Control Cucumber Grey Mould (Botrytis cinerea) under Commercial Greenhouse Conditions. Plant Pathol. 1993, 42, 324–332. [Google Scholar] [CrossRef]
- da Silva, M.A.F.; de Moura, K.E.; de Moura, K.E.; Salomão, D.; Patricio, F.R.A. Compatibility of Trichoderma Isolates with Pesticides Used in Lettuce Crop. Summa Phytopathol. 2018, 44, 137–142. [Google Scholar] [CrossRef]
- Barakat, R.M.; Al-Masri, M.I. Effect of Trichoderma harzianum in Combination with Fungicides in Controlling Gray Mould Disease (Botrytis cinerea) of Strawberry. Am. J. Plant Sci. 2017, 08, 651–665. [Google Scholar] [CrossRef]
- Ji, X.; Li, J.; Meng, Z.; Zhang, S.; Dong, B.; Qiao, K. Synergistic Effect of Combined Application of a New Fungicide Fluopimomide with a Biocontrol Agent Bacillus methylotrophicus TA-1 for Management of Gray Mold in Tomato. Plant Dis. 2019, 103, 1991–1997. [Google Scholar] [CrossRef] [PubMed]
- Ladi, E.; Shukla, N.; Bohra, Y.; Tiwari, A.K.; Kumar, J. Copper Tolerant Trichoderma asperellum Increases Bio-Efficacy of Copper against Phytophthora infestans in Dual Combination. Phytoparasitica 2020, 48, 357–370. [Google Scholar] [CrossRef]
- Fagnano, M.; Agrelli, D.; Pascale, A.; Adamo, P.; Fiorentino, N.; Rocco, C.; Pepe, O.; Ventorino, V. Copper Accumulation in Agricultural Soils: Risks for the Food Chain and Soil Microbial Populations. Sci. Total Environ. 2020, 734, 139434. [Google Scholar] [CrossRef]
- El-Nahhal, I.; El-Nahhal, Y. Pesticide Residues in Drinking Water, Their Potential Risk to Human Health and Removal Options. J. Environ. Manag. 2021, 299, 113611. [Google Scholar] [CrossRef]
- Qin, G.; Chen, Y.; He, F.; Yang, B.; Zou, K.; Shen, N.; Zuo, B.; Liu, R.; Zhang, W.; Li, Y. Risk Assessment of Fungicide Pesticide Residues in Vegetables and Fruits in the Mid-Western Region of China. J. Food Compos. Anal. 2021, 95, 103663. [Google Scholar] [CrossRef]
- Atlas, R.M.; Pramer, D.; Bartha, R. Assessment of Pesticide Effects on Non-Target Soil Microorganisms. Soil Biol. Biochem. 1978, 10, 231–239. [Google Scholar] [CrossRef]
- Yang, C.; Hamel, C.; Vujanovic, V.; Gan, Y. Fungicide: Modes of Action and Possible Impact on Nontarget Microorganisms. Int. Sch. Res. Not. 2011, 2011, 130289. [Google Scholar] [CrossRef]
- Leroch, M.; Plesken, C.; Weber, R.W.S.; Kauff, F.; Scalliet, G.; Hahn, M. Gray Mold Populations in German Strawberry Fields Are Resistant to Multiple Fungicides and Dominated by a Novel Clade Closely Related to Botrytis cinerea. Appl. Environ. Microbiol. 2013, 79, 159–167. [Google Scholar] [CrossRef]
- Abbey, J.A.; Percival, D.; Abbey, L.; Asiedu, S.K.; Prithiviraj, B.; Schilder, A. Biofungicides as Alternative to Synthetic Fungicide Control of Grey Mould (Botrytis cinerea)—Prospects and Challenges. Biocontrol Sci. Technol. 2019, 29, 207–228. [Google Scholar] [CrossRef]
- Butt, T.M.; Jackson, C.; Magan, N. (Eds.) Fungi as Biocontrol Agents: Progress Problems and Potential; CABI Publishing: Oxon, UK; New York, NY, USA, 2001; ISBN 978-0-85199-356-0. [Google Scholar]
- Vinale, F.; Sivasithamparam, K.; Ghisalberti, E.L.; Woo, S.L.; Nigro, M.; Marra, R.; Lombardi, N.; Pascale, A.; Ruocco, M.; Lanzuise, S.; et al. Trichoderma Secondary Metabolites Active on Plants and Fungal Pathogens. Open Mycol. J. 2014, 8, 127–139. [Google Scholar] [CrossRef]
- Asad, S.A. Mechanisms of Action and Biocontrol Potential of Trichoderma against Fungal Plant Diseases—A Review. Ecol. Complex. 2022, 49, 100978. [Google Scholar] [CrossRef]
- Lambrese, Y.; Sansone, G.; Sanz, M.I.; Di Masi, S.N.; Raba, J.; Calvente, V. Kosakonia radicincitans and Cryptococcus laurentii Controlled Penicillium expansum Rot and Decreased Patulin Production at 4 and 25 °C. Food Microbiol. 2021, 100, 103863. [Google Scholar] [CrossRef] [PubMed]
- Jochum, C.C.; Osborne, L.E.; Yuen, G.Y. Fusarium Head Blight Biological Control with Lysobacter enzymogenes Strain C3. Biol. Control. 2006, 39, 336–344. [Google Scholar] [CrossRef]
- Anand, T.; Chandrasekaran, A.; Kuttalam, S.; Senthilraja, G.; Samiyappan, R. Integrated Control of Fruit Rot and Powdery Mildew of Chilli Using the Biocontrol Agent Pseudomonas fluorescens and a Chemical Fungicide. Biol. Control. 2010, 52, 1–7. [Google Scholar] [CrossRef]
- Zhang, C.; Wang, W.; Xue, M.; Liu, Z.; Zhang, Q.; Hou, J.; Xing, M.; Wang, R.; Liu, T. The Combination of a Biocontrol Agent Trichoderma asperellum SC012 and Hymexazol Reduces the Effective Fungicide Dose to Control Fusarium Wilt in Cowpea. J. Fungi 2021, 7, 685. [Google Scholar] [CrossRef]
- Rusjan, D. Copper in Horticulture. In Fungicides for Plant and Animal Diseases; Dhanasekaran, D., Ed.; InTech: London, UK, 2012; pp. 257–278. ISBN 978-953-307-804-5. [Google Scholar]
- Valarmathi, P.; Pareek, S.K.; Priya, V.; Rabindran, R.; Chandrasekar, G. Compatibility of Copper Hydroxide (Kocide 3000) with Biocontrol Agents. IOSR-J. Agric. Vet. Sci. 2013, 3, 28–31. [Google Scholar] [CrossRef]
- Blanco, C.; de los Santos, B.; Romero, F. Relationship between Concentrations of Botrytis cinerea Conidia in Air, Environmental Conditions, and the Incidence of Grey Mould in Strawberry Flowers and Fruits. Eur. J. Plant Pathol. 2006, 114, 415–425. [Google Scholar] [CrossRef]
- Elad, Y.; Williamson, B.; Tudzynski, P.; Delen, N. Botrytis spp. and Diseases They Cause in Agricultural Systems—An Introduction. In Botrytis: Biology, Pathology and Control; Elad, Y., Williamson, B., Tudzynski, P., Delen, N., Eds.; Springer Netherlands: Dordrecht, The Netherlands, 2007; pp. 1–8. ISBN 978-1-4020-2626-3. [Google Scholar]
- van den Bosch, F.; Paveley, N.; Shaw, M.; Hobbelen, P.; Oliver, R. The Dose Rate Debate: Does the Risk of Fungicide Resistance Increase or Decrease with Dose? Plant Pathol. 2011, 60, 597–606. [Google Scholar] [CrossRef]
- Karlovsky, P. Inhibition of Imidazolegly Cerolphosphate Dehydratase of Phytophthora parasitica by Aminotriazole in situ and after Cloning and Expression of the Respective Gene (HIS3) in Escherichia coli. J. Phytopathol. 1994, 141, 121–126. [Google Scholar] [CrossRef]
- Abbott, W.S. A Method of Computing the Effectiveness of an Insecticide. J. Econ. Entomol. 1925, 18, 265–267. [Google Scholar] [CrossRef]
- Forbes, G.A.; Pérez, W.; Adrade-Piedra, J. Field Assessment of Resistance in Potato to Phytophthora Infestans: International Cooperators Guide; International Potato Center: La Molina, Lima, Peru, 2014; ISBN 978-92-9060-440-2. [Google Scholar]




| Treatment | Inhibition [%] | |||
|---|---|---|---|---|
| Mycelial Growth | Sporulation | |||
| Control | Trichoderma spp. | 0 | def | 0 |
| SW | T10 | 100 | a | 99.6 |
| T16 | 50 | abcd | 84.4 | |
| T19 | 70.8 | ab | 93.2 | |
| T23 | 100 | a | 96.6 | |
| TVSC | 54 | abc | 71 | |
| water | 100 | a | 100 | |
| SC | T10 | 100 | a | 80.8 |
| T16 | 100 | a | 98 | |
| T19 | 99.7 | a | 90.7 | |
| T23 | 100 | a | 99.9 | |
| TVSC | 100 | a | 100 | |
| water | 100 | a | 100 | |
| OR | T10 | 15.8 | cdef | 27.3 |
| T16 | −1.7 | def | −93.8 | |
| T19 | −2.6 | def | 59 | |
| T23 | 30.3 | bcdef | 34.5 | |
| TVSC | 43.4 | bcde | 54.8 | |
| water | 100 | a | 100 | |
| CP | T10 | 3.6 | cdef | −9.1 |
| T16 | −11.7 | f | −140.6 | |
| T19 | 9.7 | cdef | −148.5 | |
| T23 | 12.8 | cdef | 3.5 | |
| TVSC | −7.2 | ef | 51.6 | |
| water | 100 | a | 100 | |
| Treatment | Pathogen | Fungicide Applied Rate [%] | BCAs | |||
|---|---|---|---|---|---|---|
| CP | OR | KOS | T16 | T23 | ||
| Untreated cont. | ||||||
| Pathogen cont. | x | |||||
| T16 | x | x | ||||
| T23 | x | x | ||||
| KOS | x | x | ||||
| CP100 | x | 100 | ||||
| CP50 | x | 50 | ||||
| CP50T16 | x | 50 | x | |||
| CP50T23 | x | 50 | x | |||
| CP50KOS | x | 50 | x | |||
| OR100 | x | 100 | ||||
| OR50 | x | 50 | ||||
| OR50T16 | x | 50 | x | |||
| OR50T23 | x | 50 | x | |||
| OR50KOS | x | 50 | x | |||
Disclaimer/Publisher’s Note: The statements, opinions and data contained in all publications are solely those of the individual author(s) and contributor(s) and not of MDPI and/or the editor(s). MDPI and/or the editor(s) disclaim responsibility for any injury to people or property resulting from any ideas, methods, instructions or products referred to in the content. |
© 2024 by the authors. Licensee MDPI, Basel, Switzerland. This article is an open access article distributed under the terms and conditions of the Creative Commons Attribution (CC BY) license (https://creativecommons.org/licenses/by/4.0/).
Share and Cite
Schierling, T.E.; Vogt, W.; Voegele, R.T.; El-Hasan, A. Efficacy of Trichoderma spp. and Kosakonia sp. Both Independently and Combined with Fungicides against Botrytis cinerea on Strawberries. Antibiotics 2024, 13, 912. https://doi.org/10.3390/antibiotics13090912
Schierling TE, Vogt W, Voegele RT, El-Hasan A. Efficacy of Trichoderma spp. and Kosakonia sp. Both Independently and Combined with Fungicides against Botrytis cinerea on Strawberries. Antibiotics. 2024; 13(9):912. https://doi.org/10.3390/antibiotics13090912
Chicago/Turabian StyleSchierling, Tom E., Wolfgang Vogt, Ralf T. Voegele, and Abbas El-Hasan. 2024. "Efficacy of Trichoderma spp. and Kosakonia sp. Both Independently and Combined with Fungicides against Botrytis cinerea on Strawberries" Antibiotics 13, no. 9: 912. https://doi.org/10.3390/antibiotics13090912
APA StyleSchierling, T. E., Vogt, W., Voegele, R. T., & El-Hasan, A. (2024). Efficacy of Trichoderma spp. and Kosakonia sp. Both Independently and Combined with Fungicides against Botrytis cinerea on Strawberries. Antibiotics, 13(9), 912. https://doi.org/10.3390/antibiotics13090912







